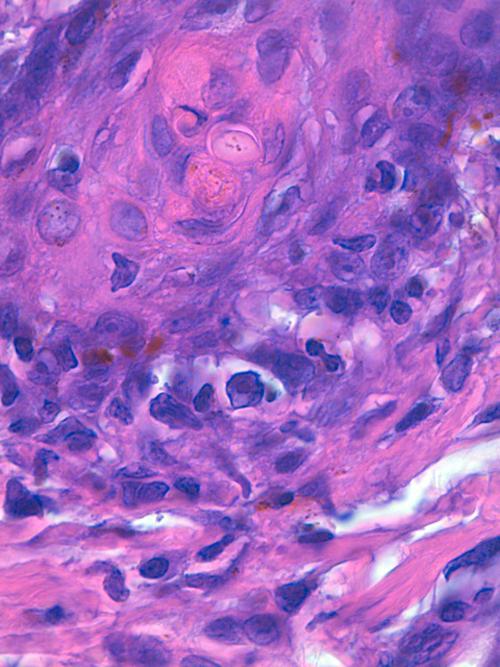

Janvier 2011
Auteurs :
Frédérique Degorce-Rubiales1 – CES de Dermatologie Vétérinaire, DESV d’Anatomie Pathologique Vétérinaire, Spécialiste en Anatomie Pathologique Vétérinaire
Agnès Poujade1 – DESV d’Anatomie Pathologique Vétérinaire, Spécialiste en Anatomie Pathologique Vétérinaire
Laurianne Personne2 – DMV
Corine Boucraut-Baralon3 – DMV, Docteur de l’Université Paul Sabatier de Toulouse (Spécialité : virologie), ancienne maître de Conférences en Pathologie infectieuse à l’ENVT, membre du groupe d’experts en pathologie infectieuse féline ABCD (European Advisory Board for Cat Diseases)
Delphine Rivière3 – DMV, CES d’Hématologie-Biochimie et ancienne chargée de consultation en biologie médicale à l’ENVT
1LAPVSO – 129 Route de Blagnac – 31201 Toulouse cedex 2 – www.lapvso.com
2Clinique vétérinaire Evolia – 43, Avenue du Chemin vert -95290 L’Isle-Adam cliniquedesetangs.com
3SCANELIS – 9 Allée Charles Cros – 31770 Colomiers www.scanelis.com
Avertissement
Le cas clinique présenté est un cas de dermatopathologie, aussi l’anamnèse, l’examen clinique, l’examen dermatologique, les examens complémentaires réalisés et les données sur le traitement entrepris, se limiteront aux données présentes sur la feuille de commémoratifs reçue avec les prélèvements histologiques.
Commémoratifs
Un chat européen, mâle castré, âgé de 1,5 an est présenté à la consultation pour une dermatose chronique très prurigineuse, localisée aux jonctions cutanéo-muqueuses de la face, aux tempes, au menton, au cou, au ventre et au pourtour unguéal. Le propriétaire signale également une chute de griffes.
Anamnèse
L’animal a été trouvé et adopté en Corse à l’âge de 1 mois. Il vit en pavillon, sort librement, n’a pas de congénères mais a de nombreux contacts avec les chats du voisinage. Il reçoit une alimentation industrielle bas de gamme, a été testé un an auparavant négatif pour le FeLV et le FIV (tests ELISA) lors de la consultation de primo-vaccination. Les vaccins (TCLR) et vermifugations sont à jour. Sa couverture ectoparasitaire est correcte. Le sujet présente une cicatrice d’un ulcère cornéen à l’œil gauche et a eu plusieurs épisodes d’ulcérations de la langue et des gencives, de sialorrhée, d’épiphora et d’abcès de la gueule. Un régime d’éviction et un traitement ectoparasitaire (à base de sélamectine) n’ont entraîné aucune amélioration de la dermatose.

Photo 1 : l’animal présente un cicatrice d’un propable ulcère cornéen à l’œil gauche
®Photo Dr L. Personne.
Photo 2 : aspect alopécique, squamo-croûteux, excorié avec micro-ulcérations du pourtour orificiel labial et du menton.
Pourtour très squameux de l’apex du pavillon auriculaire
®Photo Dr L. Personne.
Photo 3 : aspect alopécique, squamo-croûteux sur le chanfrein,
la zone supra-oculaire et la base de l’oreille
®Photo Dr L. Personne.
Photo 4 : aspect alopécique et squamo-croûteux en face externe
des pavillons auriculaires, surtout à droite
®Photo Dr L. Personne.
Photo 5 : : aspect alopécique et squamo-croûteux du pourtour
apical du pavillon auriculaire droit
®Photo Dr L. Personne.
Photo 6 : aspect squameux et crevassé du pourtour des coussinets,
présence d’une pustule et d’une micro-ulcération de la peau interdigitée
®Photo Dr L. Personne.
Photo 7 : présence de plages alopéciques et squamo-croûteuses sur les membres
®Photo Dr L. Personne.
Hypothèses diagnostiques
- Pyodermite
- Dermatophytie
- Dermatite virale (herpèsvirose principalement)
- Pemphigus superficiel
- Dermatose à cellules géantes liée au FeLV
Examens complémentaires
- Raclages : absence d’éléments figurés
- Trichogramme : absence d’éléments figurés
- Bactériologie : E. Coli sensible à l’amoxicilline
- Culture fongique : négative
- NFS dans les normes
- Bilan biochimique urée, créat, glycémie ALT PAL Na, k, Pt : dans les normes
- Tests ELISA FeLV FIV : FeLV positif FIV négatif
- DualDiag Viroses Cutanées Félines ND : biopsies cutanées pour examen dermatopathologique et PCR/Rt-PCR en temps réel sur biopsies cutanées, mais également sur cellules oro-pharyngées et cellules conjonctivales (FeLV, FIV, Calicivirus félin, Herpèsvirus félin)
EXAMEN DualDiag Viroses cutanées Félines ND
Examen histologique
Quatre biopsies cutanées sont réalisées à la base d’une griffe, au pourtour nasal et en zone supra-oculaire.
L’épiderme et les infundibula folliculaires sont le siège d’une acanthose irrégulière modérée à marquée et d’une hyperkératose orthokératosique marquée (Photo 8). L’épiderme est parfois le siège d’une spongiose mucineuse et les cellules épithéliales peuvent apparaître balonnisées (Photo 16). L’épiderme est multifocalement exulcéré à ulcéré et tapissé d’un enduit pustulo-croûteux sérocellulaire riche en neutrophiles (pustulose neutrophilique) (Photo 8, 9, 15, 20, 22) avec parfois présence d’un feutrage bactérien bleuté (Photo 11 & 12). Sur deux biopsies, on observe très nettement dans l’épiderme et dans la gaine épithéliale folliculaire externe, la présence de cellules géantes épithéliales syncitiales plurinucléées (Photo 21,23,24,25,26).
Certaines biopsies montrent au sein de la couche basale des structures épithéliales des lésions de nécrose individuelle des cellules épithéliales (Fig19) et parfois un infiltrat d’interface lymphocytaire (Fig18 & 19). Dans le derme certains vaisseaux capillaires montrent un infiltrat pariétal et des lésions de leurs cellules endothéliales (Photo 17). Des micro-ulcérations siégeant sur des zones de nécrose de liquéfaction de l’épiderme et du derme superficiel sont focalement visibles (Photo 10, 11,12). On observe un oedème dermique (Photo 11) et une leucostase neutrophilique au sein des vaisseaux capillaires.
Une biopsie montre d’importants remaniements inflammatoires du derme sous la forme d’un infiltrat neutrophilique à pyogranulomateux, diffus, cellulitique, entourant les annexes folliculo-sébacées (Fig13 & 14). Aucun élément figuré ni parasitaire ni fongique n’est visible. On n’identifie pas non plus nettement d’inclusion virale spécifique.
Conclusion de l’examen histologique
aspect histologique d’une dermatite à cellules épithéliales syncitiales géantes.
PCR en temps réel ou RT-PCR en temps réel
• Biopsie cutanée
- Calicivirus félin Positif 1,25.104 copies / analyse [charge virale élevée]
- FeLV *Positif 3,58.107 copies/ analyse [charge virale très élevée]
- FIV Négatif
- Herpèsvirus félin Négatif
• Cellules oro-pharyngées
- Calicivirus félin Positif 2,61.105 copies/ analyse [charge virale élevée]
- FeLV Positif 5,8.107 copies/ analyse [charge virale très élevée]
- FIV Négatif
- Herpèsvirus félin Négatif
• Cellules conjonctivales
- Calicivirus félin Positif 2,43.102 copies [charge virale faible]
- FeLV Positif 2,12.107 copies/ analyse [charge virale très élevée]
- FIV Négatif
- Herpèsvirus félin Négatif
*Détection du provirus (génome du virus intégré dans le génome du chat, essentiel dans le cycle de réplication des rétrovirus) et l’ARN viral (traduit une réplication virale)
Conclusion des recherches virales : présence d’une charge élevée du provirus/virus FeLV dans le prélèvement cutané. Par ailleurs, des charges très élevées de provirus/ARN viral FeLV ont été détectées dans les prélèvements oro-pharyngés et oculaires. Le calicivirus était également présent dans ces deux prélèvements avec une charge importante dans le prélèvement oro-pharyngé.
La détection d’ une charge élevée de calicivirose dans le prélèvement cutané est en faveur d’une calicivirose systémique (difficile à confirmer sur les autres prélèvements analysés qui sont des lieux de portage classique). La charge de calicivirus félin est un peu plus faible dans le prélèvement conjonctival, ce qui est classique (le virus se réplique peu dans la conjonctive oculaire). Absence de détection d’herpèsvirus félin au niveau oculaire au moment du prélèvement (mais possibilité de kératite herpétique évoluée sans détection virale. Le calicivirus est parfois impliqué dans des kératites en l’absence d’herpès virus félin)
La charge de FeLV est similaire dans tous les prélèvements, mais une leucose féline évolue rarement en 15j.
Conclusion concertée DualDiag Viroses Cutanées Félines
Aspect histologique d’une dermatite féline à cellules géantes dans un contexte de calicivirose probablement systémique et d’une infection active par un virus leucémogène félin.
Photo 8 (Hémalun Eosine X 40) : L’épiderme et les infundibula folliculaires
sont hyperplasiques et fortement hyperkératosiques. Le derme montre une inflammation péri-vasculaire.
Légendes de la Photo 8 :
- Double flèche jaune : épiderme (portion non kératinisée)
- Double flèche bleue : couche cornée hyperkératosique
- Double flèche orange : derme
- Étoiles vertes : follicules pileux
- Étoiles rouges : infiltrat dermique périvasculaire
Photo 9 (Hémalun Eosine X 100): l’épiderme est excorié et tapissé d’un
enduit pustulo-croûteux pluristratifié.
Le derme est œdémateux et montre une inflammation péri-vasculaire.
Légendes de la Photo 9 :
- Double flèche violette : couche cornée épidermique pustulo-croûteuse
- Double flèche bleue : épiderme (portion non kératinisée)
- Double flèche jaune : derme
- Étoiles rouges : infiltrat inflammatoire dermique péri-vasculaire
- Étoiles vertes : follicules pileux
- Étoiles noires : glandes sudorales épitrichiales
- Triangles bleus : pustules séro-cellulaires neutrophiliques au sein de la couche cornée
Photo 10 (Hémalun-Eosine X100): L’épiderme est ulcéré.
L’épiderme et le derme superficiel sont nécrotiques.
Légendes de la Photo 10 :
- Double flèche bleue : l’épiderme est absent (ulcère) et le derme superficiel est nécrotique. Les flèches indiquent la portion nécrosée.
- Double flèche jaune : derme
- Étoiles vertes : follicules pileux
- Étoiles rouges : infiltrat inflammatoire dermique péri-vasculaire
- Étoiles noires : glandes sébacées
- Triangle vert : une tige pilaire
- Triangle bleu : feutrage bactérien à la surface de l’ulcère
Photo 11 (Hémalun-Eosine X200) : Vue rapprochée de la Photo 10 montrant
la zone de nécrose intéressant l’épiderme et le derme superficiel, tapissée
d’un feutrage bactérien bleuté et dans laquelle affluent des granulocytes neutrophiles.
Le derme périannexiel est œdémateux.
Légendes de la Photo 11 :
- Double flèche bleue : l’épiderme est absent (ulcère) et le derme superficiel est nécrotique. Les flèches indiquent la portion nécrosée.
- Étoiles vertes : follicules pileux
- Étoile noire : muscle arrecteur du poil
- Triangle vert : odème dermique
- Triangle bleu : feutrage bactérien à la surface de l’ulcère
Photo 12 (Hémalun-Eosine X400): Vue rapprochée de la Photo 11 montrant
la zone de nécrose intéressant l’épiderme et le derme superficiel, tapissée d’un feutrage
bactérien bleuté et dans laquelle affluent des granulocytes neutrophiles. Le derme est œdémateux.
Légendes de la Photo 12 :
- Double flèche bleue : l’épiderme est absent (ulcère) et le derme superficiel est nécrotique. Les flèches indiquent la portion nécrosée. Nécrose de liquéfaction
- Étoiles vertes : granulocytes neutrophiles altérés (pycnose, caryolyse, caryorrhexie)
- Étoile rouge : capillaire sanguin
- Étoile noire : une tige pilaire
- Triangle bleu : feutrage bactérien à la surface de l’ulcère
Photo 13 (Hémalun Eosine X 200): Sous des zones d’ulcération de l’épiderme,
le derme superficiel et le derme périannexiel peuvent être le siège d’un dense
infiltrat diffus cellulitique à prédominance neutrophilique.
Légendes de la Photo 13 :
- Étoiles bleues : follicules pileux
- Étoiles noires : glandes sudorales épitrichiales
- Étoile rouge : capillaire sanguin
- Triangles verts : dense infiltrat diffus cellulitique à prédominance neutrophilique
Photo 14 (Hémalun Eosine X 400) : Vue rapprochée de la Photo 13.
Sous des zones d’ulcération de l’épiderme, le derme superficiel et le derme périannexiel
peuvent être le siège d’un dense infiltrat diffus cellulitique, riche en
granulocytes neutrophiles, en macrophages et en plasmocytes.
Légendes de la Photo 14 :
- Étoiles vertes : un follicule pileux (en haut à gauche) et granulocytes neutrophiles
- Étoile jaune : glande sudorale épitrichiale
- Étoile rouge : capillaire sanguin
- Triangles verts : cellules inflammatoires d’allure macrophagique
- Traingles bleus : œdème dermique
Photo 15 (Hémalun Eosine X 100) : L’épiderme et les infundibula folliculaires
sont hyperplasiques et fortement hyperkératosiques et sièges de lésions vésiculo-pustuleuses.
Ces structures épithéliales semblent anormalement cellulaires.
Le derme montre une inflammation péri-vasculaire.
Légendes de la Photo 15 :
- Double flèche bleue : couche cornée de l’épiderme, hyperkératosique (orthokératose)
- Triangles bleus : pustulose neutrophilique intra-cornée et dans la paroi ou la lumière des infundibula follicualires
- Triangles verts : zones anormalement cellulaires au sein de l’épiderme et des infundibula folliculaires
- Ronds marrons : follicules pileux
- Étoiles rouges : infiltrat dermique péri-vasculaire
Photo 16 (Hémalun Eosine X 1000 objectif à immersion dans l’huile) :
L’épiderme peut montrer une spongiose discrètement mucineuse.
Légendes de la Photo 16 :
- Flèches jaunes : elles pointent l’odème intercellulaire ou spongiose, d’allure bleutée (spongiose mucineuse)
- Étoiles vertes : acanthocytes vacuolisés (ballonisation cytoplasmique)
- Triangles bleus : cellules mononucléées dans l’infiltrat inflammatoire dermique
- Triangles jaunes : granulocytes neutrophiles dans l’infiltrat inflammatoire dermique
- Triangle vert : zone centrale kératinisée d’un follicule pileux (infundibulum)
Photo 17 (Hémalun Eosine X 1000 objectif à immersion dans l’huile):
Le derme superficiel, périannexiel et profond montre un infiltrat inflammatoire de topographie
périvasculaire, de nature mixte, associant plasmocytes, lymphocytes et granulocytes neutrophiles.
Certaines cellules endothéliales semblent lésées (noyau pâle ballonisé).
Légendes de la Photo 17 :
- Triangles verts : œdème dermique dissociant les trousseaux de fibres de collagène
- Rond rouge : il délimite un capillaire sanguin
- Étoiles rouges : cellules inflammatoires dans la lumière, autour au dans la paroi d’un capillaire sanguin
- Ronds marrons : trousseaux de fibres de collagène
- Traingle haune : cellule endothéliale lésée à noyau pâle et ballonisé
Photo 18 (Hémalun Eosine X 1000 objectif à immersion dans l’huile) :
L’interface dermo-épidermique, comme l’interface dermo-épithéliale
des follicules pileux, est soulignée d’un infiltrat à prédominance lymphocytaire.
Légendes de la Photo 18 :
- Flèche bleue : follicule pileux (infundibulum)
- Flèche verte : derme périannexiel
- Triangle vert : centre kératinisé du follicule pileux
- Flèches jaunes : elles pointent des cellules inflammatoires lymphocytaires à l’interface du follicule pileux (infiltrat inflammatoire d’interface)
- Étoiles vertes : dégénérescence hydropique de cellules basales de la gaine folliculaire externe
Photo 19 (Hémalun Eosine X 1000 objectif à immersion dans l’huile) :
L’interface dermo-épidermique, comme l’interface dermo-épithéliale des follicules pileux,
est soulignée d’un infiltrat à prédominance lymphocytaire.
Quelques corps apoptotiques isolés et basaux, y sont perceptibles.
Légendes de la Photo 19 :
- Flèche bleue : follicule pileux (infundibulum)
- Flèche verte : derme périannexiel
- Flèches jaunes : elle pointe un lymphocyte à l’interface du follicule pileux (infiltrat inflammatoire d’interface)
- Étoiles rouges : cellules épithéliales basales apoptotiques au sein de la gaine folliculaire externe
Photo 20 (Hémalun Eosine X 200): Vue rapprochée de la Photo 15.
L’épiderme et les infundibula folliculaires sont hyperplasiques et fortement hyperkératosiques et sièges de lésions vésiculo-pustuleuses.
Un foyer de folliculite pustuleuse murale est visible. Ces structures épithéliales semblent anormalement
cellulaires avec des noyaux épithéliaux très basophiles et très rapprochés les uns des autres.
Le derme montre une inflammation péri-vasculaire à diffuse.
Légendes de la Photo 20 :
- Double flèche bleue : épiderme
- Double flèche violette : derme
- Ronds marrons : follicules pileux ou tiges pilaires
- Flèches jaunes : pustules neutrophiliques intra-épidermiques
- Flèche orange : folliculite murale pustuleuse (pustules neutrophiliques)
- Ronds rouges : zones épidermiques ou infundibulaires anormalement cellulaires avec des noyaux épithéliaux très basophiles et très rapprochés les uns des autres
- Ronds verts : infiltrat dermique péri-vasculaire
Photo 21 (Hémalun Eosine X 400): L’épiderme et les infundibula folliculaires
sont hyperplasiques et semblent anormalement cellulaires avec des noyaux épithéliaux
très basophiles et très rapprochés les uns des autres. Les states épithéliales semblent
désorganisées et dysplasiques. Le derme montre une inflammation mixte péri-vasculaire à diffuse.
Légendes de la Photo 21 :
- Double flèche bleue : épiderme
- Double flèche violette : derme
- Ronds marrons : follicules pileux ou tiges pilaires
- Flèches jaunes : infiltrat inflammatoire mixte péri-vasculaire à diffus
- Ronds rouges : zones épidermiques ou infundibulaires anormalement cellulaires avec des noyaux épithéliaux très basophiles et très rapprochés les uns des autres
Photo 22 (Hémalun Eosine X 400): Vue rapprochée de la Photo 20. L’épiderme et les infundibula folliculaires sont hyperplasiques et sièges de lésions vésiculo-pustuleuses. Un foyer de folliculite pustuleuse murale est visible. Ces structures épithéliales sont anormalement cellulaires avec des noyaux épithéliaux très basophiles et très rapprochés les uns des autres. Plusieurs cellules kératinocytaires géantes plurinucléées sont visibles au sein de l’épiderme et d’une gaine épithéliale folliculaire externe. Le derme montre une inflammation péri-vasculaire à diffuse.
Légendes de la Photo 22 :
- Ronds rouges : cellules kératinocytaires géantes plurinucléées au sein de l’épiderme et d’une gaine épithéliale folliculaire externe
- Ronds verts : pustulose neutrophilique
- Ronds marrons : lumières folliculaires
- Flèches jaunes : infiltrat inflammatoire dermique périvasculaire à diffus riche en neutrophiles
- Étoiles rouges : capillaires
Photo 23 (Hémalun Eosine X 1000 objectif à immersion dans l’huile): Vue rapprochée
d’une cellule épithéliale géante plurinucléée syncitiale au sein d’un infundibulum folliculaire.
Plusieurs noyaux basophiles (au moins trois noyaux) à nucléole proéminent
sont visibles au sein d’un même cytoplasme basophile.
Légendes de la Photo 23 :
- Grande étoile verte : cellule épithéliale géante plurinucléée syncitiale au sein d’un infundibulum folliculaire
- Flèche verte : derme
- Flèche bleue : follicule pileux (infundibulum)
- Rond marron : tige pilaire
- Rond rouge : pustules neutrophiliques folliculaires murales
- Petites étoiles vertes : granulocytes neutrophiles
Photo 24 (Hémalun Eosine X 1000 objectif à immersion dans l’huile) : Vue rapprochée
d’une cellule épithéliale géante plurinucléée syncitiale au sein d’un infundibulum folliculaire.
Plusieurs noyaux basophiles à nucléole proéminent sont visibles au sein
d’un même cytoplasme basophile (au moins onze noyaux visibles).
Légendes de la Photo 24 :
- Grande étoile verte : cellule épithéliale géante plurinucléée syncitiale au sein d’un infundibulum folliculaire
- Rond rouge : pustule neutrophilique folliculaire murale
- Triangle vert : granulocyte neutrophile
Photo 25 (Hémalun Eosine X 1000 objectif à immersion dans l’huile) : Vue rapprochée
d’une cellule épithéliale géante plurinucléée syncitiale au sein d’un infundibulum folliculaire.
Plusieurs noyaux basophiles à nucléole proéminent sont visibles au sein
d’un même cytoplasme basophile (au moins quatre noyaux visibles).
Légendes de la Photo 25 :
- Flèches jaunes : elles cernent une cellule épithéliale géante plurinucléée syncitiale au sein d’un infundibulum folliculaire
- Étoile verte : un noyau de la cellule syncitiale
Photo 26 (Hémalun Eosine X 1000 objectif à immersion dans l’huile): Vue rapprochée
d’une cellule épithéliale géante plurinucléée syncitiale au sein d’un infundibulum folliculaire.
Plusieurs noyaux basophiles à nucléole proéminent sont visibles au sein
d’un même cytoplasme basophile (au moins onze noyaux visibles avec une anisocaryose).
Légendes de la Photo 26 :
- Flèches jaunes : elles cernent une cellule épithéliale géante plurinucléée syncitiale au sein d’un infundibulum folliculaire
- Étoile verte : un noyau de la cellule syncitiale
Traitement
- Antibiothérapie à base d’amoxicilline (selon résultat de la bactériologie et de l’antibiogramme)
Évolution
- à 15 j :
- Amélioration des lésions cutanées
- Diminution état général : diminution d’appétit, baisse de forme
- Amaigrissement net
- à 16j :
- Signes digestifs : vomissements toute la nuit
- Amorphe, décubitus latéral
- Ictère
- Hospitalisation : perfusion, traitement symptomatique des vomissements, radiographie du thorax et échographie abdominale normales
- Coma
- Décision d’euthanasie par les propriétaires
Discussion
- Dans différentes espèces animales la présence de syncitia cellulaires épithéliaux suggère une infection virale (maladie de carré dans l’espèce canine par exemple), dans l’espèce féline cette présence n’a été rapportée que dans le cadre de la dermatose féline à cellules géantes, dermatose rare, décrite chez des chats infectés par le FeLV et qui n’a pas été particulièrement rapportée dans le cadre d’autres infections virales à tropisme cutané.
- Un grand nombre de lésions cutanées ont été décrites comme étant associées au FeLV : abcès récidivant, cellulite, paronychie, néoplasies cutanées, prurit sévère et mauvaise cicatrisation, mais la plupart du temps c’est l’immunodépression induite par le FeLV qui permet d’expliquer la survenue de ces affections.
- Deux syndromes cutanés différents ont été décrits comme résultant de l’effet cytopathogène du FeLV : la dermatose à cellules géantes et les cornes cutanées chez le chat.
- Gross et al (1993) ont émis l’hypothèse que la formation de syncitia n’était pas la conséquence d’un effet cytopathogène direct du virus, mais témoignerait d’une transformation carcinomateuse de cellules épithéliales.
- Rohn et al (1998) ont démontré que des variants particuliers du FeLV pouvaient induire la formation de syncitia cellulaires et Favrot et al (2005) sont plutôt en faveur du fait que des variants particuliers du FeLV pourraient exprimer des effets cytopathogènes cutanés, dont la formation de syncitia épithéliaux.
- Il est donc possible que la dermatose à cellules géantes résulte du pouvoir pathogène d’un variant particulier et rare du FeLV.
- Les symptômes cutanés de la dermatose féline à cellules géantes se caractérisent par des lésions prurigineuses de la face (paupières, régions pré-auriculaires, menton, lèvres), des pavillons auriculaires (otite ulcérative), du cou et parfois du tronc, par des lésions alopéciques squameuses et croûteuses.
Des symptômes généraux (anorexie, léthargie, amaigrissement) sont observés.
Des études immuno-histochimiques utilisant des anticorps anti-GP70 ont démontré la présence de l’antigène GP70 chez tous les chats, uniquement dans les zones cutanées contenant des cellules géantes. Par ailleurs, des études immuno-histochimiques de la peau de chats infectés par le FeLV ne présentant pas de dermatose à cellules géantes n’expriment pas l’antigène GP70.
Aucun traitement n’existe. Le pronostic est très sombre. Les chats dont les cas ont été rapportés dans la littérature vétérinaire, sont décédés ou ont été euthanasiés dans les 4 mois. Le cas décrit n’a pas échappé à ce pronostic sombre. - Le calicivirus est un virus à tropisme épithélial et endothélial qui, pour certaines souches, peut être à l’origine de signes cutanés :
- Dermatite pustuleuse et nécrosante décrite en 2005 par Declercq chez deux chattes vaccinées, survenant sur leur plaie d’ovariectomie avec ou sans symptômes respiratoires, caractérisée histologiquement par une nécrose épidermique et une pustulose neutrophilique panépidermique avec infiltrat inflammatoire dermique mixte diffus.
- Syndrome « pieds Mains Bouche» (“paw and mouth ») auquel sont associées des lésions lympho-prolifératives buccales et à localisation principalement podale survenant chez de jeunes chats de 2 mois à 4 ans, y compris des sujets correctement vaccinés, sous la forme d’ulcérations focales très symétriques des coussinets ou en regard des articulations des membres (surtout carpale et tarsale) associées à une atteinte du philtrum nasal, des lèvres ou de la langue, parfois sans symptomatologie respiratoire. Ce syndrome est assimilable au syndrome “pieds-mains-bouche” du jeune enfant. On constate en général de prime abord un oedème douloureux des articulations et des membres (le châton peut même boiter) puis une petite ulcération focale, la symptomatologie clinique s’exprimant sur une période de 7 à 14j. Les lésions guérissent spontanément ou après un traitement symptomatique (décrit initialement par Sabine 1972, rapporté par Malik et Norris 2011; décrit par Declercq GEDAC Arcachon 2007).
- Syndrome fébrile suivi d’ulcérations périanales précédant la guérison (décrit initialement par Sabine, Love et Zuber, rapporté par Malik et Norris 2011)
- Syndrome systémique sévère dû à des souches hypervirulentes (Pesavento, 2004) à l’origine d’œdèmes sous-cutanés de la face et des membres, de lésions alopéciques des membres et du ventre, d’ulcères (macroscopiques mais parfois uniquement microscopiques) dans la cavité buccale, sur la langue, les oreilles, à la jonction peau des coussinets / peau interdigitée, au bord des narines. Histologiquement on note une nécrose segmentaire totale de l’épiderme et des cellules endothéliales (cytolyse). Une atteinte viscérale est associée (nécrose hépatique, hépatite, pneumonie, nécrose splénique et pancréatique).
- Certains auteurs ont émis l’hypothèse que les lésions cutanées d’ulcération (dermatite pustuleuse post-ovariectomie décrite par Declercq et syndrome “pieds mains bouche” décrit par Sabine, seraient secondaires à l’inoculation cutanée du virus via le léchage de l’animal (l’entrée du virus serait facilitée par la plaie chirurgicale ou les micro-lésions induites par le lèchage lui-même).
- Cependant des lésions de dermatose à cellules géantes n’ont jamais été décrites lors d’une infection par le calicivirus.
- Dans notre cas, les charges virales de FCV détectées, dans les lésions cutanées, sont importantes pour cette localisation et sont peut être la conséquence de l’immunodépression provoquée par l’infection rétrovirale ou le fait d’une souche de calicivirus à tropisme cutané. Le calicivirus peut également avoir participé au développement de certaines lésions décrites chez ce chat (ulcérations cutanées macroscopiques et microscopiques, discrète dermatite d’interface pauci-cellulaire rappelant une dermatopathie ischémique, ictère / atteinte hépatique ou coagulopathie?).
Bibliographie
- Rohn JL, Moser MS, Gwynn SR et al. In vivo Évolution of a novel, syncytium-inducing feline leukemia virus variant. J. Virol. 1998; 72: 2686–96.
- Favrot C, Grest P, Meli M, Kipar A, Wilhelm S and Zaugg N : P-32 Giant cell dermatosis in a FeLV-infected cat : detection of the virus in infected skin by immunohistology and PCR. Vet Dermatol. 2004, Aug;15(1): 50.
- Pesavento P, MacLachlan N, Dillard-Telm L, Grant C and Hurley K Pathologic, immunohistochemical, and Electron Microscopic Findings in naturally occuring virulent systemic feline calicivirus infection in cats. Vet. Pathol 2004 41 : 257-263.
- Declercq J : Pustular calicivirus dermatitis on the abdomen of two cats following routine ovariectomy. Vet. Dermatol., 2005, Decemb;16 (6) : 395-400.
- Favrot C, Wilhelm S, Grest P, Meli ML, Hofmann-Lehmann R, Kipar A.Two cases of FeLV-associated dermatoses. Vet Dermatol. 2005 Dec;16(6):407-12.
- Gross TL, Clark E, Hargis AM, Headi| LL, Haines DM : Giant Cell Dermatosis in FeLV-positive Cats. Vet Dermatol. 2008 Mars 3(4): 117 – 122.
- Malik R1, Norris JM NAVDF : Herpes and Other Viral Dermatoses, proceedings North american Veterinary Dermatology Forum april 13-16, 2011 Calveston, Texas USA, 61-67.